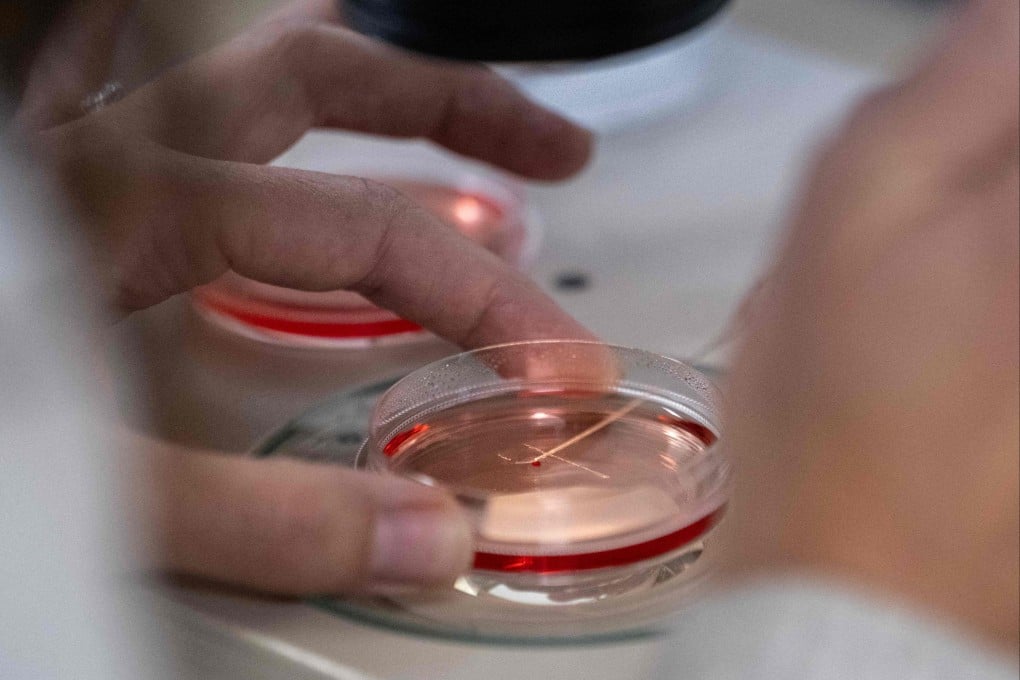
An Israeli hospital says it has achieved a breakthrough in cultivating kidneys in laboratories. Photo: AFP

Israeli hospital that pioneers lab-grown kidneys seeks China biotech funding
The team has ‘a huge interest in Chinese and Hong Kong biotech companies’, says project lead Benjamin Dekel
An Israeli hospital that has achieved a breakthrough in cultivating kidneys in laboratories is seeking funding, including from China, to advance into clinical trials, according to the project’s lead researcher.
Sheba Medical Centre, in collaboration with Tel Aviv University, said it had successfully grown a synthetic 3D organ culture, or organoid, that was the first to survive beyond 34 weeks, marking a significant milestone in regenerative medicine. Previous attempts had not exceeded four weeks, according to Benjamin Dekel, director of Sheba’s paediatric nephrology unit and Stem Cell Research Institute.
The innovative potential of kidney organoids is substantial, according to Dekel. They allow researchers to model kidney diseases, facilitating a better understanding of their underlying mechanisms and enabling timely interventions. Furthermore, drug tests can be conducted on human-like kidney organoids instead of relying solely on lab tests performed on mice.
“I’m very, very optimistic about the path forward,” Dekel said. “It doesn’t involve cell transplantation, [but rather] the molecules [the organoid] secretes.” The biomolecule secretions possess properties that could help repair injured kidneys, he added.

Dekel is now focused on translating lab success into medical treatments.